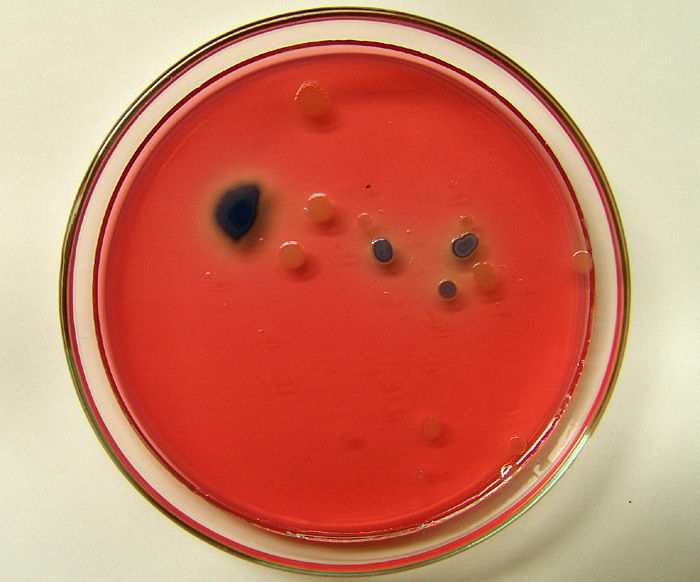

Willem Paul de Mooij
Hoofdredacteur VMT
Willem Paul de Mooij is hoofdredacteur van VMT. Binnen VMT schrijft hij vooral over het thema Voedselveiligheid & Kwaliteit.

Hoofdredacteur VMT
Willem Paul de Mooij is hoofdredacteur van VMT. Binnen VMT schrijft hij vooral over het thema Voedselveiligheid & Kwaliteit.


Energiereductie wordt de komende jaren een heel belangrijk thema voor de voedingsmiddelenindustrie. Dit onderwerp zal ook uitgebreid aan bod komen op de beurs Industrial Processing en World of Technology & Science (WoTS) van 4 tot 7 oktober in de Utrechtse Jaarbeurs.

PostNL krijgt steeds meer interesse van voedselproducenten die producten willen distribueren via het netwerk van de postbezorger. Naast bezorgkoelboxen test PostNL nu ook eenmalige gekoelde verpakkingen voor bijvoorbeeld maaltijden.

De levensmiddelenindustrie gaf in april aan met consumenten, ngo's en andere stakeholders in dialoog te willen om een digitale keukentafel. Die komt er nu. Het online dialoogplatform heet 'Nederland Voedselland' en wordt op 13 oktober gelanceerd door staatssecretaris Martijn van Dam van Economische Zaken.

Voor de invulling van de voedselagenda komt 20 miljoen euro beschikbaar. Dat blijkt uit de plannen die op Prinsjesdag zijn gepresenteerd.
UPDATE MET CORRECTE THT-DATA Supermarktketen Jumbo heeft in overleg met de NVWA besloten om een aantal rundertartaarproducten terug te halen. Het betreft een preventieve maatregel in verband met de mogelijke aanwezigheid van de E. coli bacterie.

Sparkel Beverages roept uit voorzorg literpakken kokosdrank van de merken King Coconut en 100% Coconut Grove terug. Dit omdat de productveiligheid niet gegarandeerd kan worden als gevolg van onvoldoende verhitting in het productieproces.

De Centrale Organisatie voor de Vleessector (COV) zegt zeer blij te zijn met het advies van de Raad van State over de kosten van handhaving, toezicht en keuring door de NVWA.

Cornelis Vrolijk Holding mag Seafood Parlevliet Holding overnemen. Dat heeft de Autoriteit Consument & Markt (ACM) op 2 september 2016 besloten.

FNLI is niet blij met het advies van de Stichting Ik Kies Bewust om het blauwe Vinkje te schrappen. De fabrikantkoepel is bang voor 'een aanloop naar chaos en veel bomen zonder bos'.

Tebodin heeft een Belgische directeur aangesteld, Johan Vanderborght (54). Hij zal focussen op de verdere groei van Tebodin in België